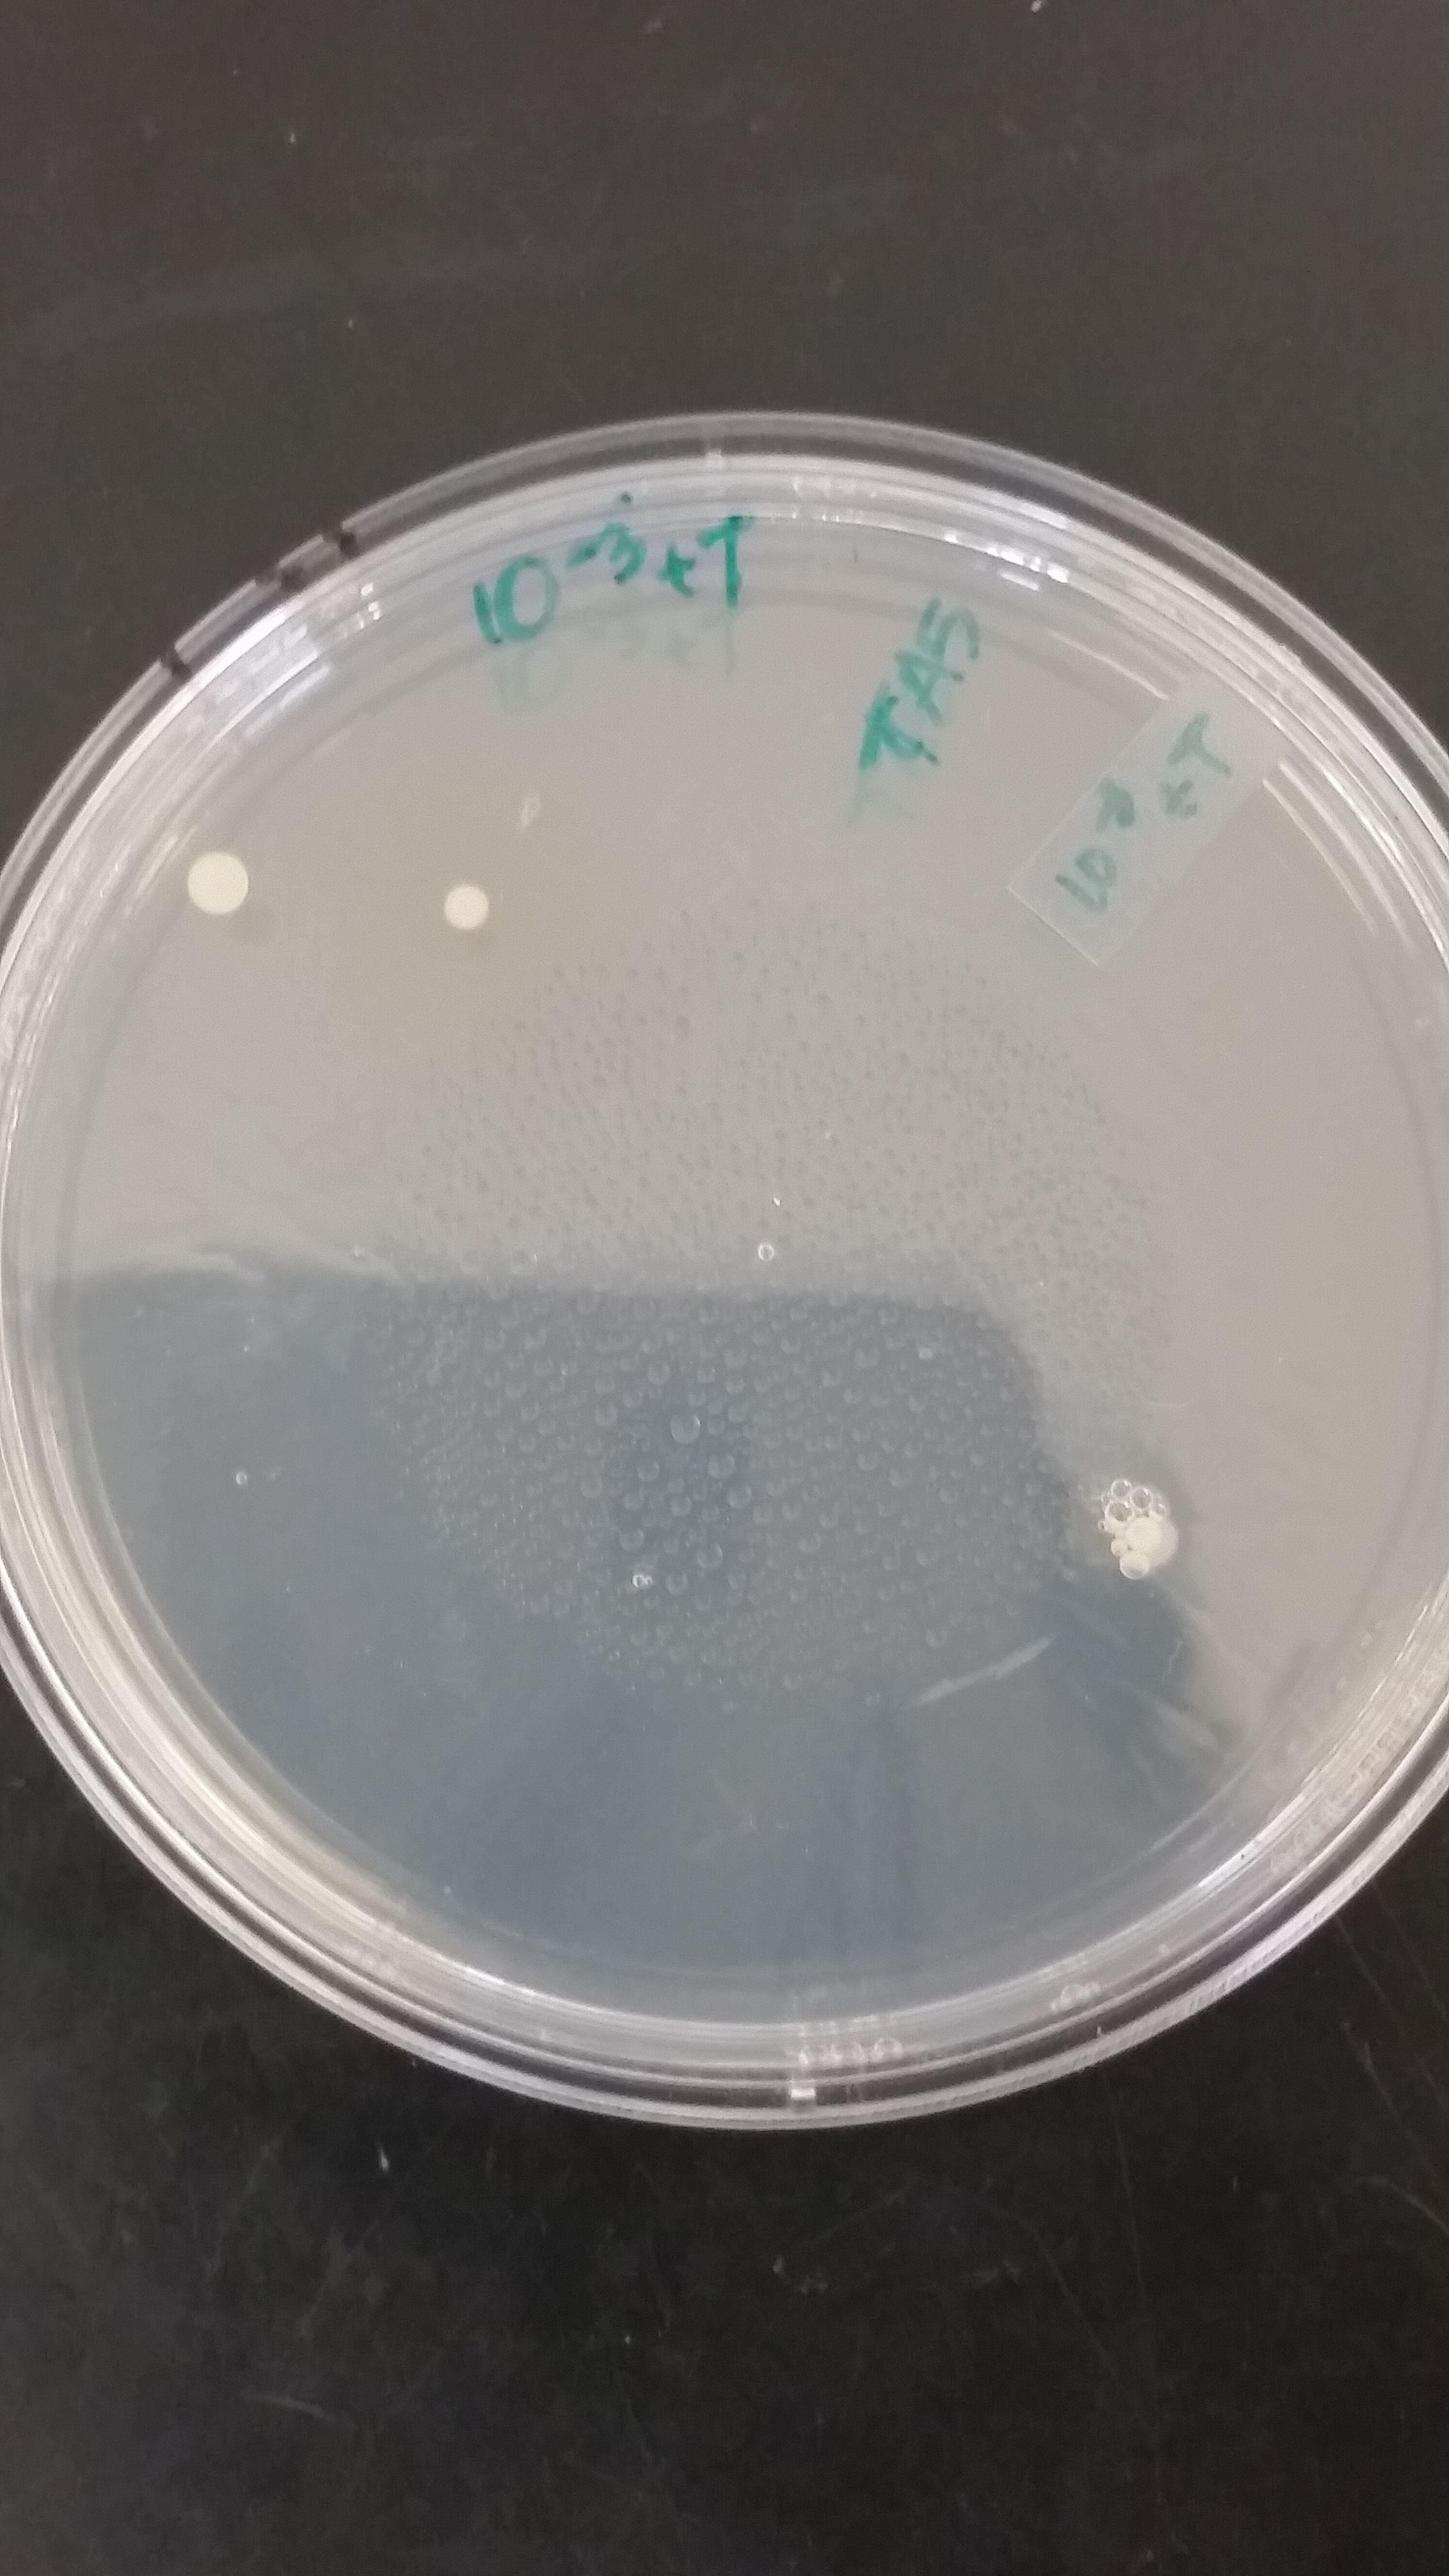
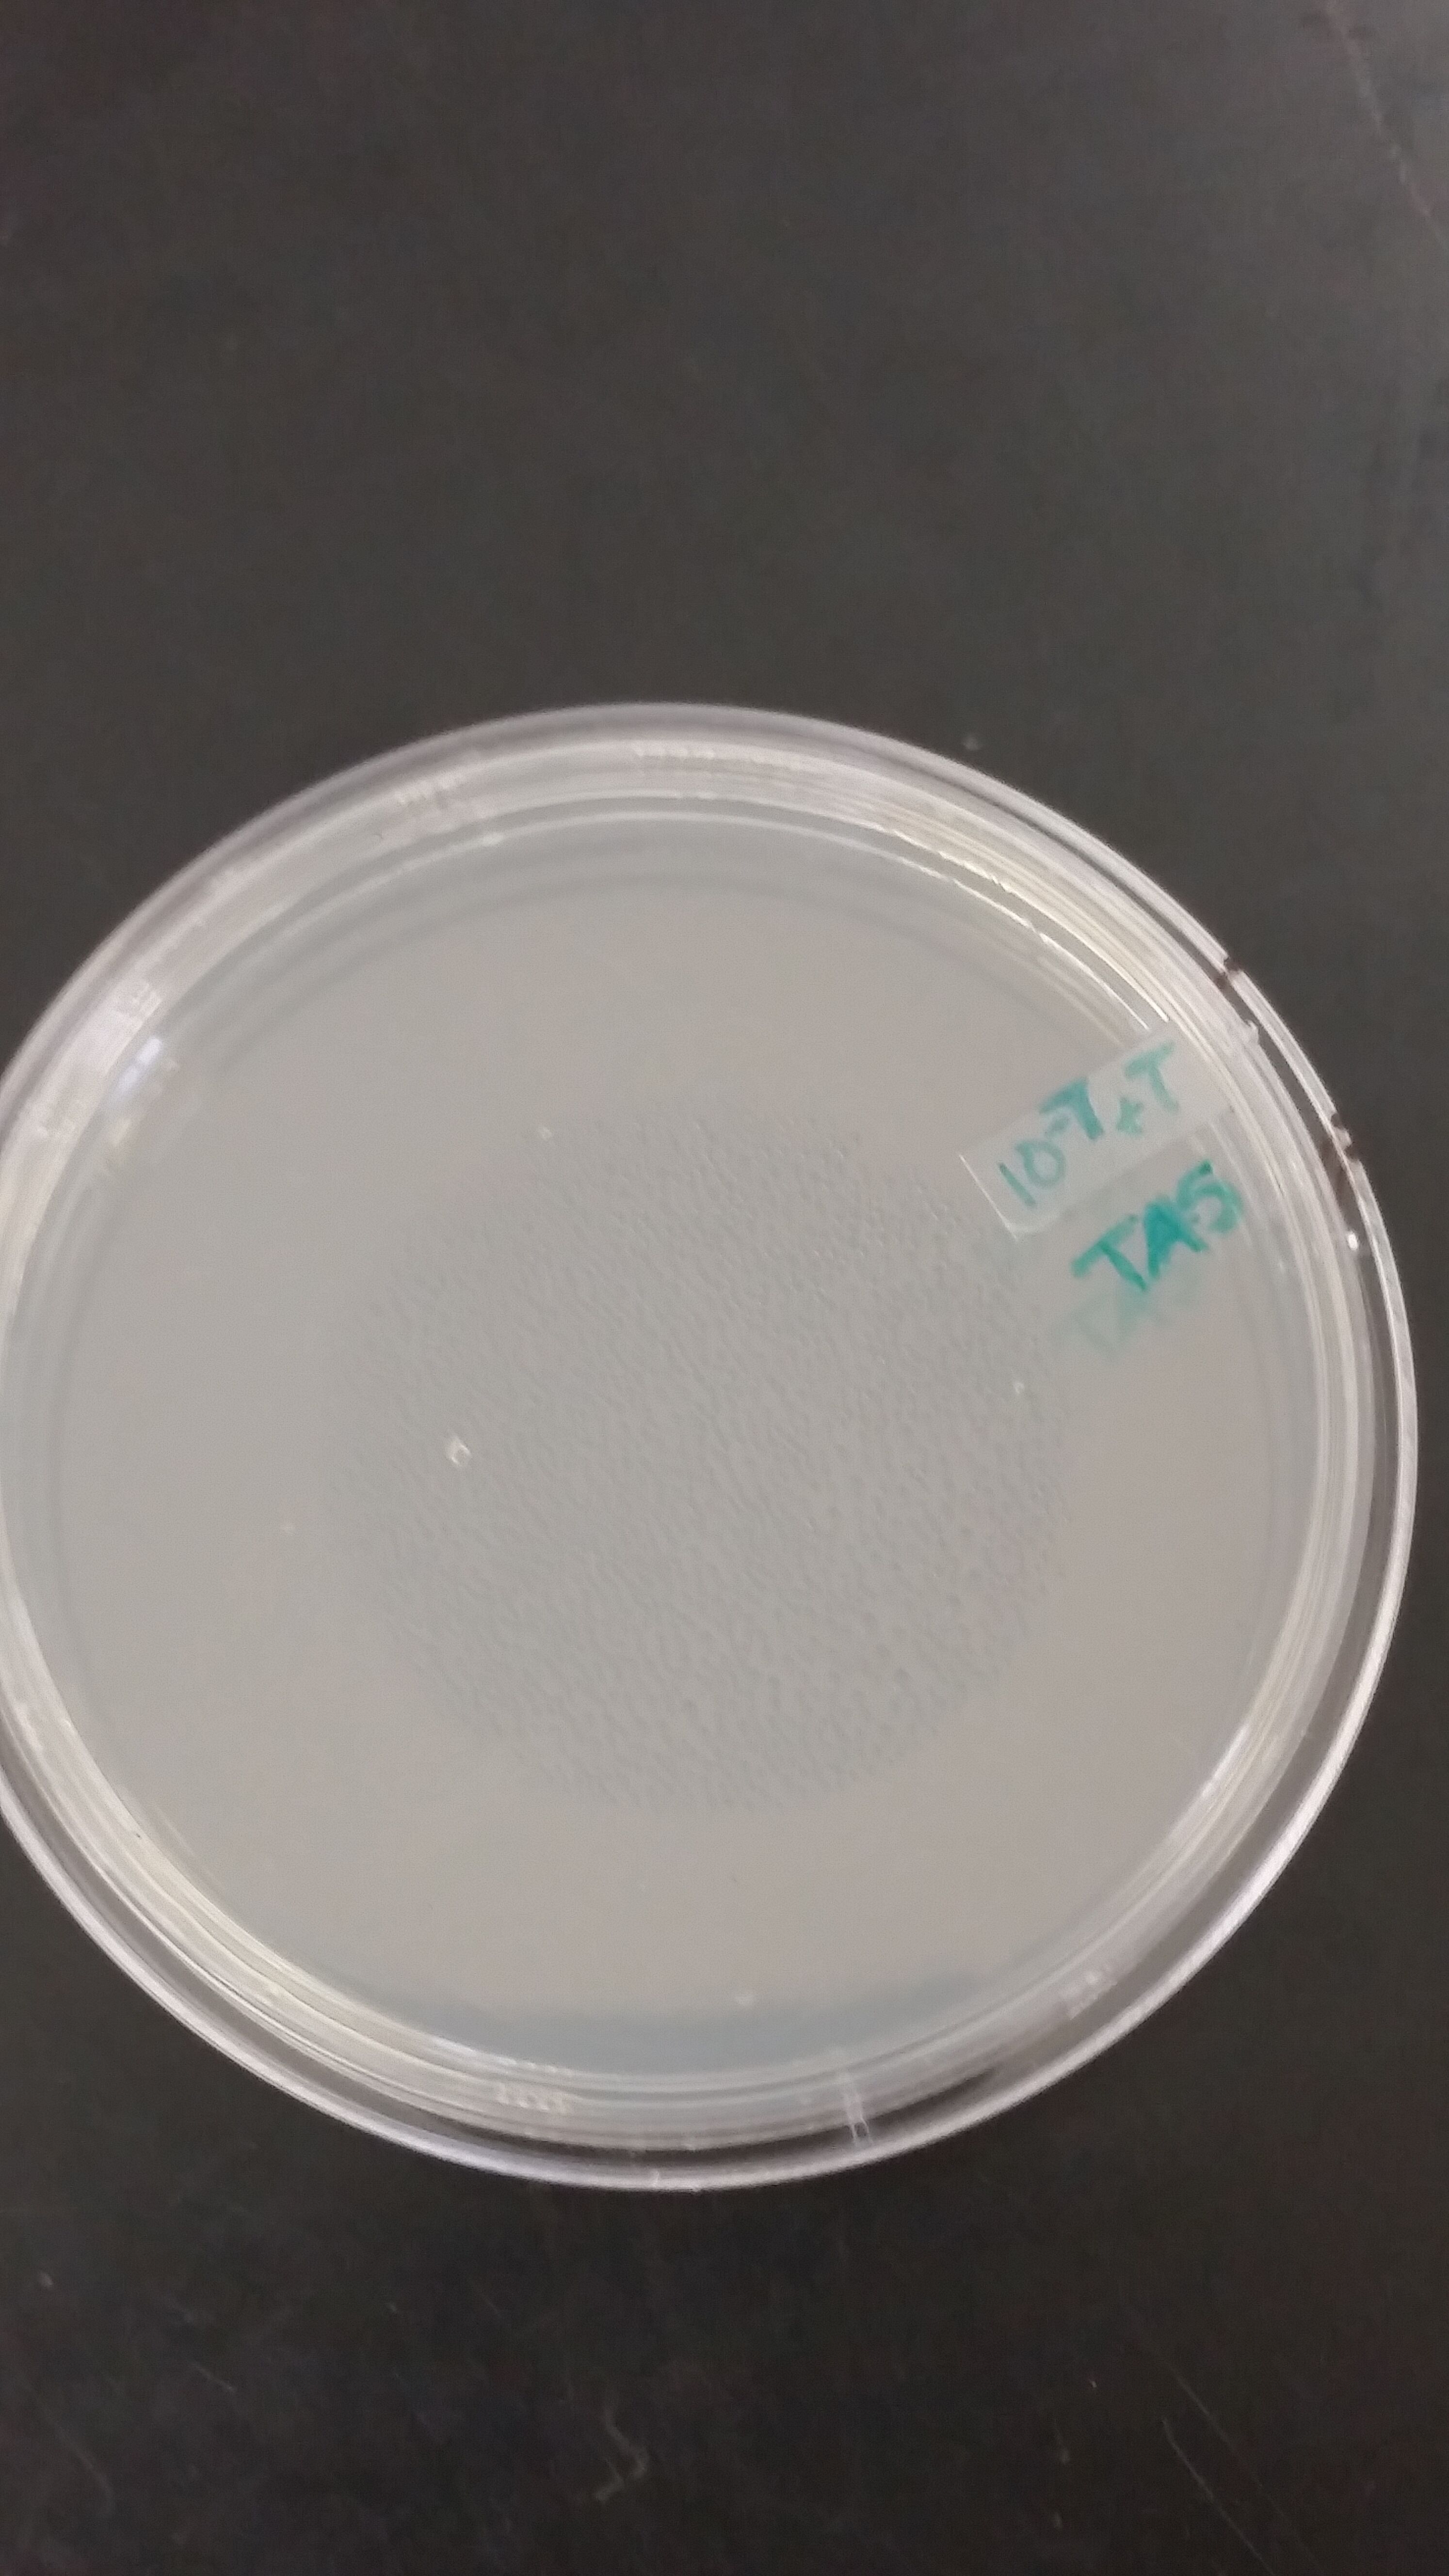
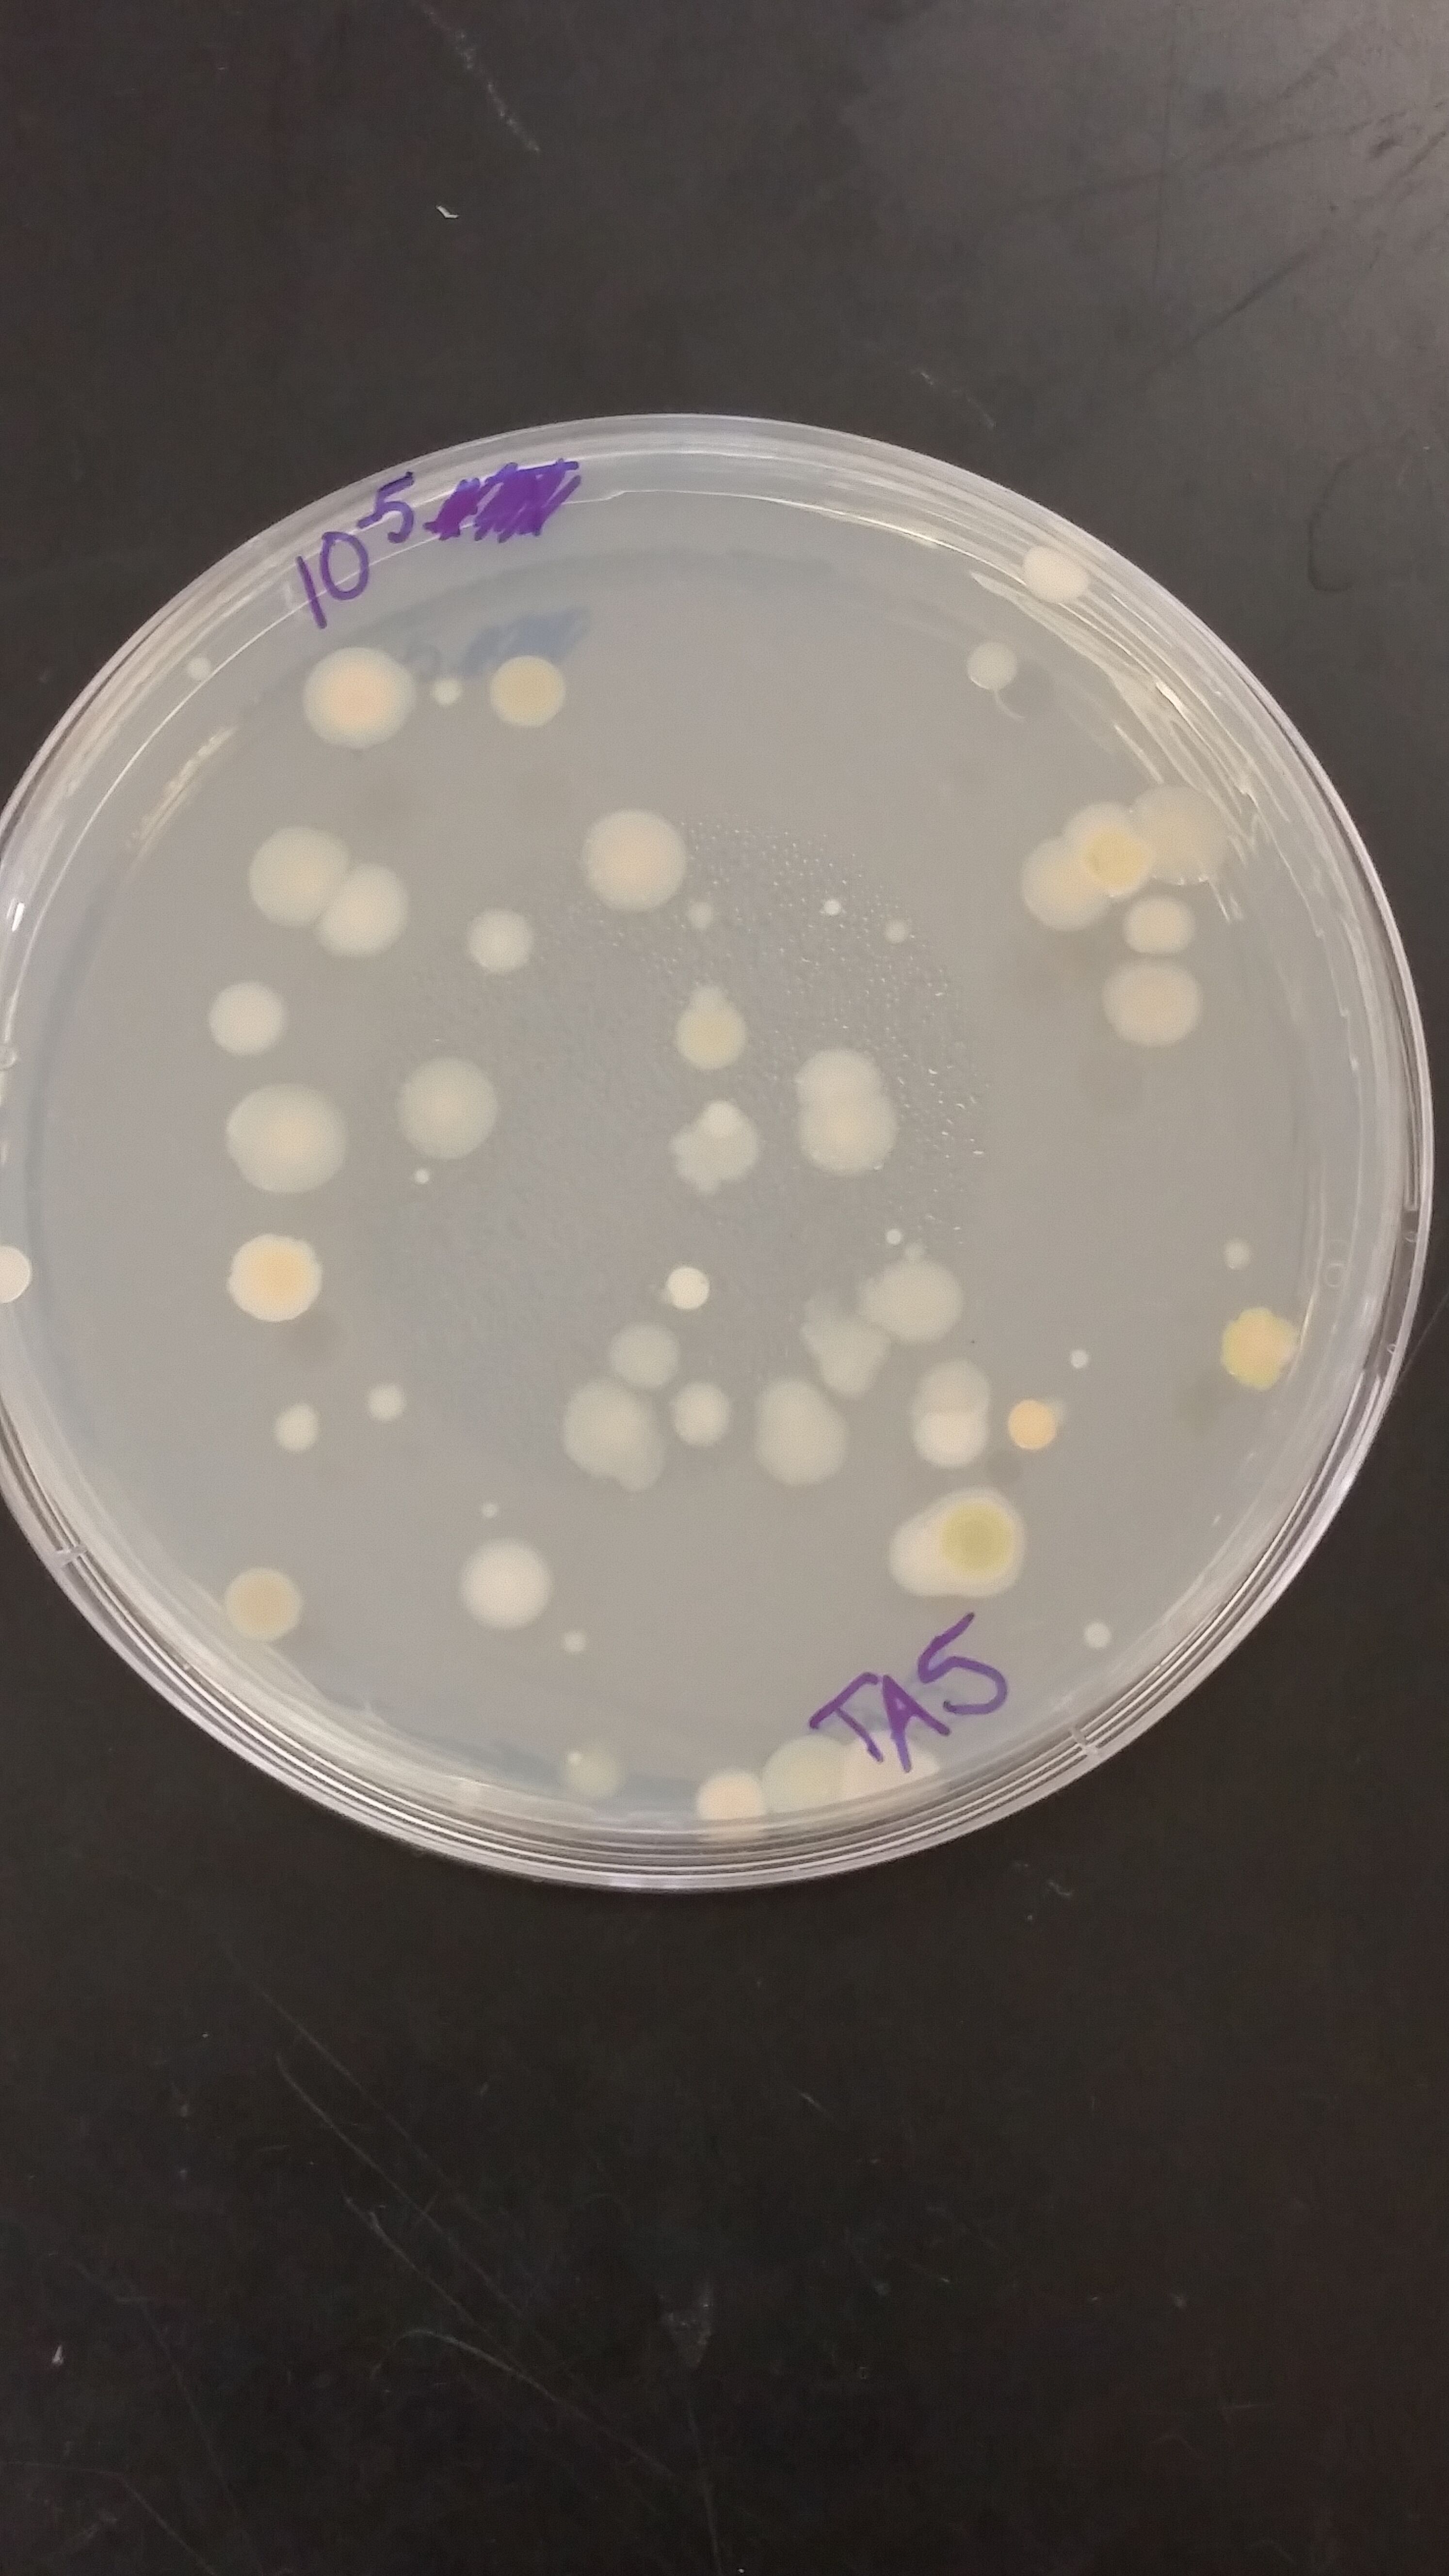
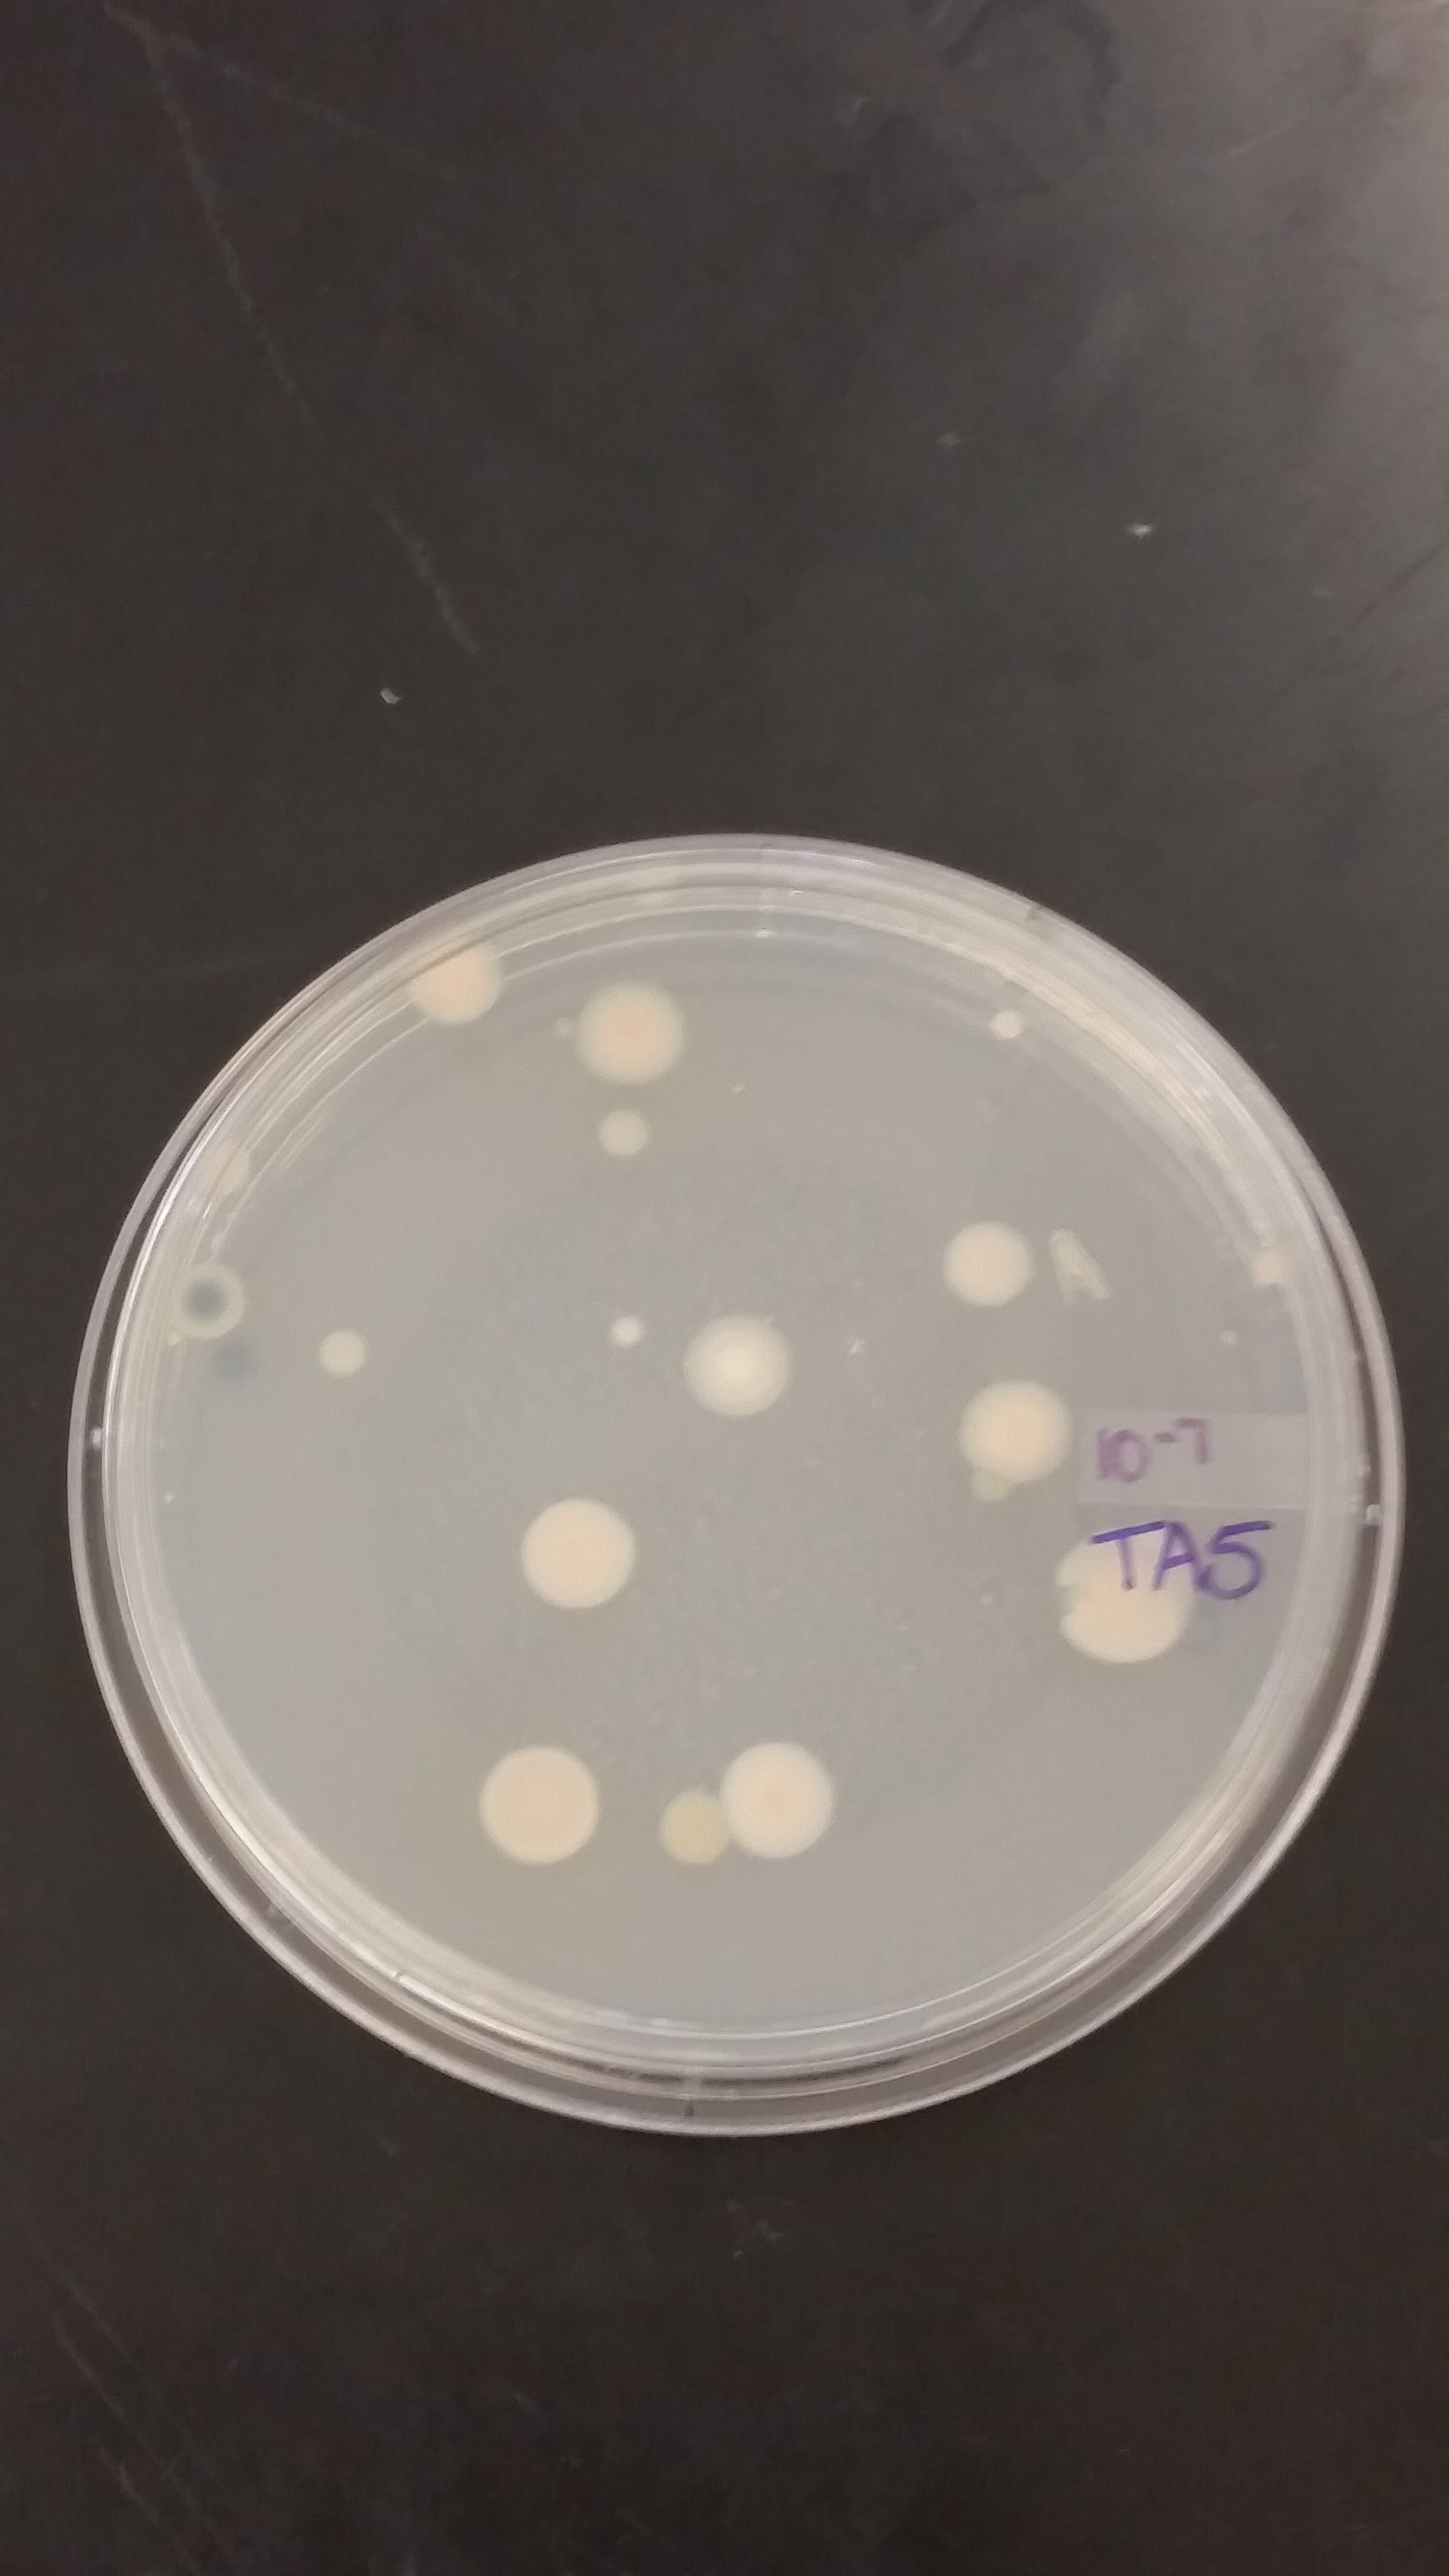
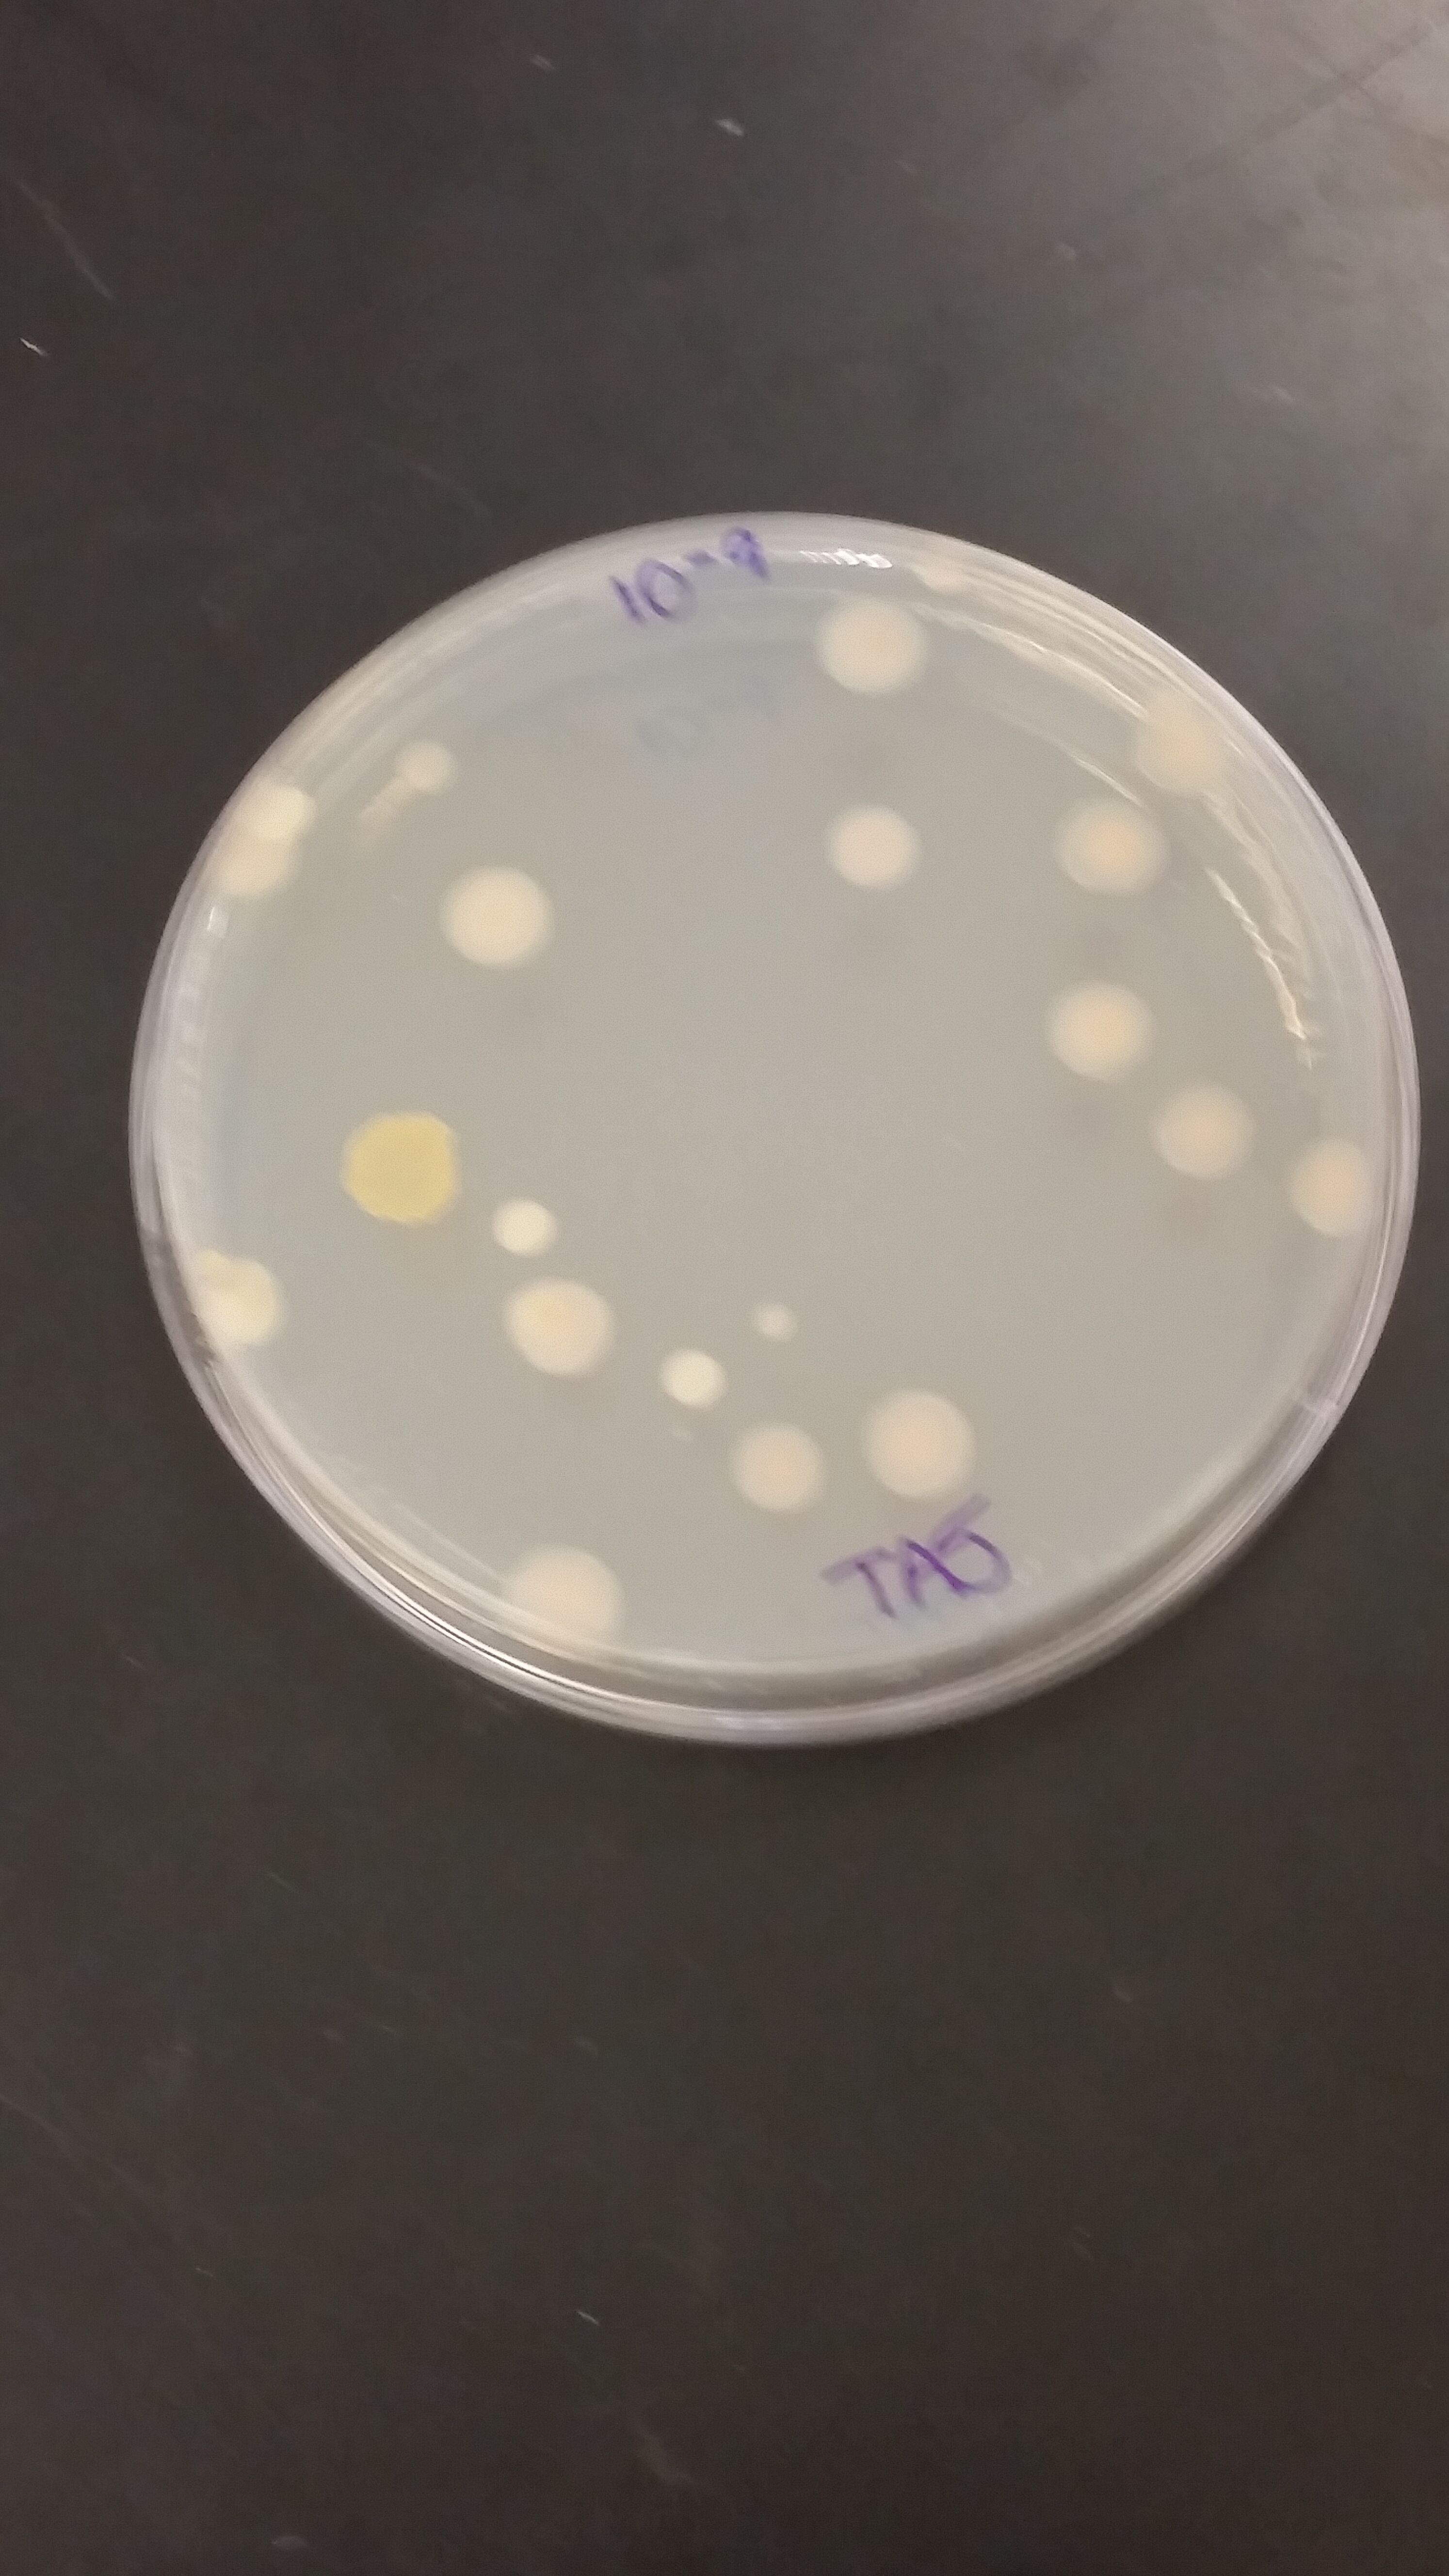

User:Tyler L. Faulkner/Notebook/Biology 210 at AU
Vertebrate Analysis and Food Web
Since our transect is enclosed by a fence most wild life and other types of animals would not have any way of accessing our transect. The only vertebrates we would assume would interact with our transect are birds because they would have access by flying into our transect. Of course, human beings as well can have access to it as well, but there is no access for vertebrates who could destroy our transect as oppose to the other transects. This also contributes to our hypothesis of a diversity of life within our transect, because it is enclosed and not many animals could disturb the growth of the produce grown in our garden.
Figure 20
From our food web, we concluded that the majority of our invertebrates were part of the Phylum Arthropoda. However, we did conclude that one of the invertebrates was a part of the Phylum Cnidaria, which we know had to have been an error on our part because our transect is not a marine ecosystem. We also found an Euglena in our Hay Infusion Culture, however we weren't sure how this type of invertebrate was related to our transect. From the Arthropods, we made a connection to the dicot plants with seeds, monocot plants with seeds, angiosperms, and dead leaves because all the invertebrates consume these as food. We also found moss on the ground of our transect near a wooden plot that was very moist. We drew a connection from rotting wood and the moss because the moss eats rotting wood. Another bacteria we found was the Colpidium which eats bacteria, and the bacteria eats the dead leaves, so there was also a connection through those organisms as well. Finally, at the top of our food chain are the bird species, because the bird species eat Arthropods and they also eat from the angiosperms. This is important as well, because cross pollination is able to occur because the birds carry specimens of pollen from one plant to the next plant they go to for food.
Zebrafish and Caffeine
Day 8:
Control Group
| Column 1 | Column 2 | Column 3 | Column 4 | Column 5 | Column 6 |
| Alive | Dead | Alive, limited movemend head twitching | Alive | Alive | Dead |
| Alive, mutation gone | Alive | Alive | Alive | Alive | Alive |
| Dead | Alive | Alive | Alive | Alive | Alive, white/clear in color |
| Alive | Alive | Alive | Alive | Alive | Alive |
Experimental Group
| Column 1 | Column 2 | Column 3 | Column 4 | Column 5 | Column 6 |
| Alive | Alive | Alive | Alive | Dead | Alive |
| Alive | Dead | Alive | Alive | Dead | Alive, very active |
| Alive | Alive | Alive | Alive, motor issues | Alive | Alive |
| Alive | Alive | Alive, 2 fish* | Dead | Dead | Alive |
We preserved two fish from the control group and one fish from experimental group. From the control group we examined the fish from Row 2, Column 5 and Row 3, Column 2.
Row 2, Column 5: - Body and body pigmentation normal, dark spots, body slightly yellow - Eye movement, very dark in color - Normal heart rate - Pectoral fin in development - Swim bladder developing - Mouth/Jaw development
Row 3, Column 2: - Body and tail pigmentation dark yellow with normal dark spots - Eye movement - Normal heart rate - Pectoral fins present and developing - Swim bladder developing - Mouth/Jaw development
From the experiment group we examined the fish from Row 2, Column 4.
Row 2, Column 4: - Body and tail pigmentation, slightly yellow, clear, dark spots - Eye movement, dark eyes - Pectoral fins developing - Swim bladder developing - Heart rate normal - Mouth development normal
Day 4 Results:
Zebrafish Control Group
| Column 1 | Column 2 | Column 3 | Column 4 | Column 5 | Column 6 |
| Alive Developed at 120hpf | Dead | Alive, small, more clear | Alive, developed at 120hpf | Alive, developed at 120 hpf | Dead |
| Mutation- yellow/green eyes, Developed at 120 hpf | Alive, Developed at 120 hpf | Alive, Developed at 120hpf | Alive, developed at 120hpf | Alive, looks to be developed at 144hpf (more developed) | Alive, looks to be developed at 144hpf (more developed) |
| Dead | Alive, looks to be developed at 144hpf (more developed) | Alive, Developed at 120hpf | Alive, developed at 120hpf | Alive, developed at 120 hpf | Alive, developed at 120 hpf |
| Alive, underdeveloped | Alive, smaller in size | Alive | Alive, developed at 120hpf | Alive, developed at 120 hpf | Alive, slightly more clear, developed at 120hpf |
For our control group all of the zebrafish were placed in fresh water.
Zebrafish Experimental Group
| Concentration | Column 1 | Column 2 | Column 3 | Column 4 | Column 5 | Column 6 |
| 100% Caffeine (2μL) | Alive, very underdeveloped, 24 hours | Alive, slightly more clear | Alive | Alive, underdeveloped | Alive, underdeveloped, 48 hours | Alive, mutation: eyes, body green/gold color |
| 75% Caffeine (1.5μL) 25% Water (.5μL) | Alive, slightly shorter in length, 36 hours | Alive, underdeveloped, 48 hours | Alive, slightly clear | Alive, slightly clear | Alive, slightly more clear | Alive, slightly clear |
| 50% Caffeine (1μL) 50% Water (1μL) | Alive, dark eyes | Alive | Alive, more clear | Alive, slightly more clear, dark eyes | Alive, clear, dark eyes | Alive, clear, darker eyes |
| 25% Caffeine (.5μL) 75% Water (1.5μL) | Alive, underdeveloped | Alive | Alive, 2 fish* | Dead | Dead | Alive |
PCR: NNNNNNNNNNNNTNNNNNNNGNNNCTCCTNNNACGNGTCACCGNCTTCAGGTACCCCATNNNNNCCATGGCTTGACGGGC GGTGTGTACAAGGCCCGGGAACGTATTCACCGCGCCATGGCTGATGCGCGATTACTAGCGATTCCAGCTTCATAGAGTCG AGTTGCAGACTCCAATCCGAACTGAGACCAGCTTTCGAGATTCGCATCCAGTCACCTGGTAGCTGCCCTCTGTACTGGCC ATTGTATTACGTGTGTGGCCCAAGGCGTAAGGGCCGTGATGATTTGACGTCATCCCCACCTTCCTCTCTACTTGCGTAGG CAGTCTCACTAGAGTCCCCAACTGAATGATGGCAACTAGTGACAGGGGTTGCGCTCGTTGCAGGACTTAACCTAACACCT CACGGCACGAGCTGACGACAACCATGCAGCACCTTGAAAAATGTCCGAAGAAAAGTCTATTTCTAAACCTGTCATTTCCC ATTTAAGCCTTGGTAAGGTTCCTCGCGTATCATCGAATTAAACCACATAATCCACCGCTTGTGCGGGCCCCCGTCAATTC CTTTGAGTTTCAGACTTGCGTCCGTACTCCCCAGGTGGCTAACTTATCACTTTCGCTTAGTCTCTGAATCCGAAAACCCA AAAACGAGTTAGCATCGTTTACGGCGTGGACTACCAGGGTATCTAATCCTGTTCGCTCCCCACGCTTTCGTCCATCAGCG TCAGTTGTTGCTTAGTAACCTGCCTTCGCAATTGGTGTTCTAAGTAATATCTATGCATTTCACCGCTACACTACTTATTC CAGCTACTTCAACAACACTCAAGACCTGCAGTATCAATGGCAGTTTCACAGTTAAGCTGTGAGATTTCACCACTGACTTA CAGATCCGCCTACGGACCCTTTAAACCCAATAAATCCGGATAACGCTTGCACCCTCCGTATTACCGCGGCTGCTGGCACG GAGTTAGCCGGTGCTTATTCGTATAGTACCTTCAGCTTNCCACACGTGGAAAGGTTNNTCCCTATACNAAAGAAGTTTAN NNCCATNNGNNNTCGNCTTCACGCGGGNTGNTGGNTCAGNTCTCANCCNTGNCNANNTCNTCANNGCTGCNTCCCGNAGN ANTCNGGNCCNNNNNNTCAGNACNNNNNGNGGGGNANNCN
Tetracycline is an antibiotic first discovered in 1940 to treat different types of bacterial infections. Tetracycline has revealed that it can inhibit growth of microorganisms, including those that are either gram-positive or gram-negative, including chlamydiae, mycoplasmas, rickettsiae, and protozoan parasites (Chopra & Roberts, 2001). However, although tetracycline is used to treat many different bacterial infections, it still has a resistance to many growing pathogenic bacteria. Many researchers have found that the increase in bacterial resistance is because new genes are created and code for energy-dependent efflux of tetracyclines (Chopra & Roberts, 2001). Since many pathogens are now resistant to tetracycline, researches are now trying to find other ways to treat infectious and noninfectious diseases.
Hay Infusion Culture:
Our transect is the garden at the northwest side of campus near the tennis courts. Many of the vegetation there now is dead or has weeds growing in their planters. However, many of the planting boxes do have labels of what type of crop is grown there. For example, some that we saw was lettuce and cauliflower. Abiotic factors: sunlight, soil, water, temperature, moisture, wind Biotic factors: worms, birds, other organisms, weeds
When we opened up our Hay Infusion Culture, surprisingly our culture did not smell bad. In fact, it smelt like fresh soil and natural. At the bottom of our jar was the buildup of dirt and on top was the water. On the top layer, we did not notice any type of mold or green shoots, however there was an apparent thin layer on the top of our water.
Pictures of our Hay Infusion Culture:
After using our dichotomous key we discovered Colpidium was present on the bottom layer of our culture. It wasn't very big, and was actually only 50μm. The top layer also had a Colpidium and was 30μm.
The Colpidium colpoda are ciliate protozoa, who are commonly found in freshwater environments. We assume that the Colpidium were found in our transect because it is a vegetable garden and with freshwater and soil.
In the middle layer we found a Euglena, which was much larger than the Colpidium found in both the bottom and top layer. The Euglena measured 450μm. Euglena are flagellate protists and are very small and long. They are unique organisms because they are to some sorts a combination of both a plant and animal, which causes them to fall in between the Animal and Plant Kingdom. However, because of this very hard distinction, scientist have place them in the Protist Kingdom.
Serial dilution procedure:
After conducting our serial dilution we found that the plates with the tetracycline inhibited the growth of bacteria better than the plates without. When comparing the same dilution level between the agar plates with just nutrients and the ones with nutrients and tetracycline there is a huge difference between the amount of colonies that grew there. A majority of our colonies grown on the agar plates were the same shape on both the plates with and without the tetracycline.
Table 1: 100-fold Serial Dilutions Results
| Dilution | Agar Type | # Colonies on Plate | Conversion Factor | Colonies/mL |
| 10^-3 | Nutrient | 134 | x10^3 | 134,000 |
| 10^-5 | Nutrient | 55 | x10^5 | 5,500,000 |
| 10^-7 | Nutrient | 23 | x10^7 | 230,000,000 |
| 10^-9 | Nutrient | 21 | x10^9 | 21,000,000,000 |
| 10^-3 | Nutrient + Tet | 3 | x10^3 | 3,000 |
| 10^-5 | Nutrient + Tet | 1 | x10^5 | 100,000 |
| 10^-7 | Nutrient + Tet | 0 | x10^7 | 0 |
| 10^-9 | Nutrient + Tet | 0 | x10^9 | 0 |
Pictures of our Serial Dilutions:
Figure 1: Serial Dilution 10^-3 + Tet
Figure 2: Serial Dilution 10^-5 + Tet

Figure 3: Serial Dilution 10^-7 + Tet
Figure 4: Serial Dilution 10^-9 + Tet

Figure 5: Serial Dilution 10^-3

Figure 6: Serial Dilution 10^-5
Figure 7: Serial Dilution 10^-7
Figure 8: Serial Dilution 10^-9
Table 2: Bacteria Characterization
| Colony Label | Plate Type | Colony Description | Cell Description | Gram + or Gram - | Additional Notes |
| 10^-3 | Tetra | Flat, White, Coccus, Smooth/Glistening | Sarcina, Circular, Motile | Gram + | On this agar plate there were only 2 colonies found |
| 10^-5 | Tetra | Flat, White with a tinge of yellow, Coccus, Smooth/Glistening | Coccus, Circular, Motile | Gram - | On this agar plate there was only 1 colony found |
| 10^-3 | Milky White/Yellow/a few blue colonies, Punctiform/Flamentous colony, A majority of the colonies were smooth/Glistening, Some rough/slightly raised colonies | Streptobaccilli, Very grouped together, Motile | Gram + | On this agar plate there were many different types of colonies that were grown. Some were spread out and others were very close and compact. At the top of the plate there was also what appeared to be a slight lawn forming. | |
| 10^-7 | Beige/White, Blue, Circular colony, Flat, Smooth/Glistening | Diplobacilli, Very close together, Motile | Gram - | On this agar plate there were a few different colonies grown. We found only one dark black/blue colony that also grew. |
Figure 9: 10^-3 + Tet
 At 10x Magnification
At 10x Magnification
Figure 10: 10^-5 + Tet
 At 10x Magnification
At 10x Magnification
Figure 11: 10^-3
 At 10x Magnification
At 10x Magnification
Figure 12: 10^-7
 At 10x Magnification
At 10x Magnification
Many of the leaves we found were from small plants along the outside of our transect. I also assume that some leaves that we also found were possible from trees near our transect that flew in. We also had several types of weeds growing on the ground and in one area found some moss. We classified all the types of leaves we found to be dicots, but they all varied in size, shape, and color.
Table 3: Characteristics of Plants Collected from the Transect
| Transect Sample Plants | Locations and # in transect | Description | Vasularization | Specialized structures | Mechanisms of Reproduction |
| #1 | Cabbage patches | Large green leaf | Vasular | Very large,some holes, waxy, firm | Seeds |
| #2 | Wooden container | Small leaf, green | Vasular | Bumpy, fuzzy texture, firm | Seeds |
| #3 | On the ground toward back of transect | Small, clustered, green | Vasular | Small, waxy, very smooth appearance | Seeds |
| #4 | Along fence | Thin, many narrow leaves | Vasular | Very skinny, smooth, waxy, long, flexible | Seeds |
| #5 | Front of transect | Deep maroon with brown spots | Vasular | Bumpy, rigid | Seeds |
Fungi:
Figure 18: Fungus surround bean and corn


The Fungi sporangia are important in the fungi's survival and the way they reproduce. In the figure above is an example of fungi that reproduce by zygosporangia. The fungus looks almost cotton-like wrapped around the bean. It is white and fuzzy with small black specs, which are the zygospores.
Invertebrates:
Table 4: Characteristics of Invertebrates Found in Transect
| Organism | Number in Sample | Description of Organism | ' | ' |
| Phylum arthropoda | 1 | Small appendages, lobster-like, gray | ||
| Phylum arthropoda | 2 | Orange, oval, bettle-like | ||
| Phylum arthropoda | 4 | Peach-tan color, many legs | ||
| Phylum cnidaria | 2 | Circular | ||
| Phylum arthropoda | 1 | White, many legs |
Figure 19:
 Image of a beetle-like insect found in our transect
Image of a beetle-like insect found in our transect
Many of the organisms that were found in the Berlese Funnel were very small. When we looked at our tube, inside appeared to also be an ant, which was one of the bigger organism we saw. However, we didn't add that to our list of organisms we looked at under the microscope. Most of the organisms that we found were part of the Phylum Arthropoda and were very small in size.
References:
Chopra, Ian., & Roberts, Marilyn. "Tetracycline Antibiotics: Mode of Action, Applications, Molecular Biology, and Epidemiology of Bacterial Resistance". Microbiology and Molecular Biology Reviews 65.2. Jun. 2001. PMC. (4 Feb. 2016) <http://www.ncbi.nlm.nih.gov/pmc/articles/PMC99026/>














